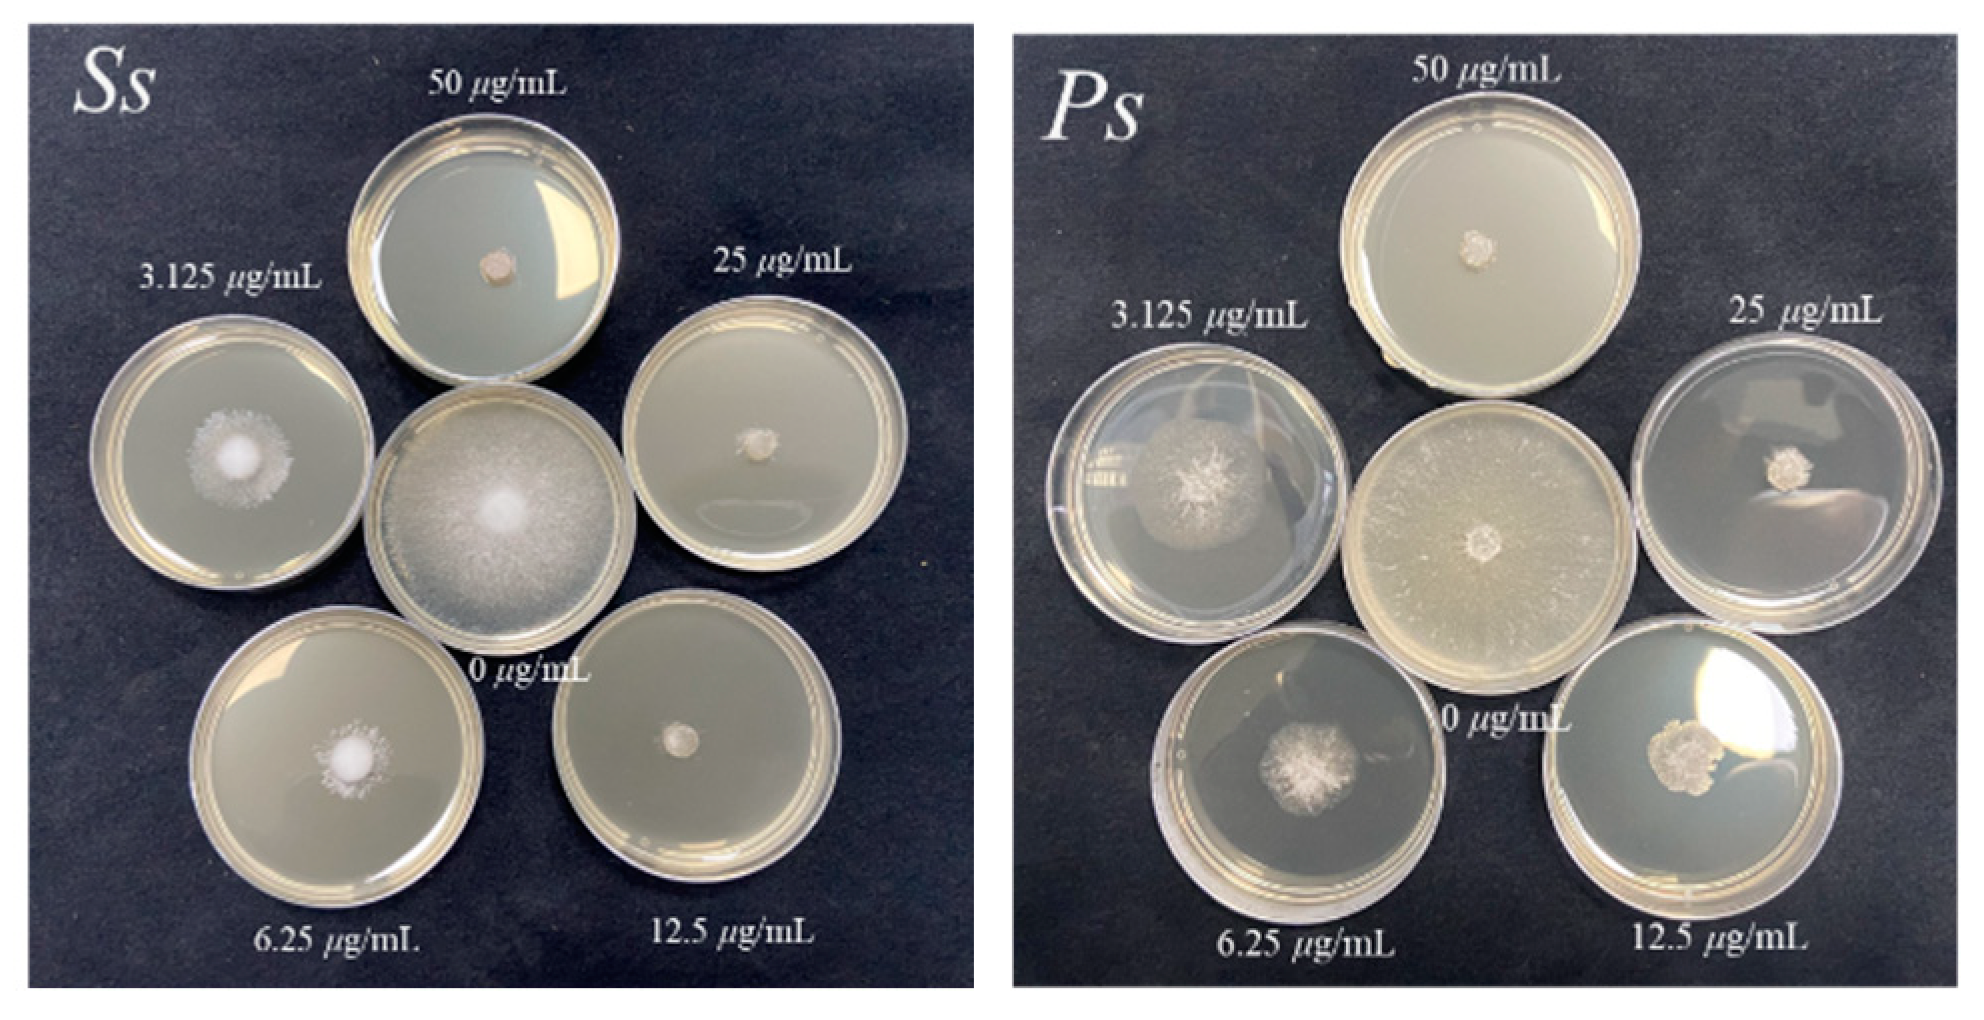

Design, Synthesis and Antifungal Activity of Novel 1,4-Pentadiene-3-one Containing Quinazolinone
Abstract
1. Introduction
2. Result and Discussion
2.1. Chemistry
2.2. In Vitro Antifungal Bioassay
2.3. In Vivo Fungicidal Activities Resist S. sclerotiorum
2.4. In Vivo Fungicidal Activities Resist Phomopsis sp.
2.5. Scanning Electron Microscopy (SEM) of Compound W12 on the Hyphae Morphology
2.6. Effect of W12 on the Cell Membrane Permeability of S. sclerotiorum
2.7. Effect of W12 on the Cytoplasmic Leakage of S. sclerotiorum
2.8. Effect of W12 on the Cytoplasmic Leakage of S. sclerotiorum
2.9. Molecular Docking
3. Materials and Methods
3.1. Instruments and Chemicals
3.1.1. General Procedure for the Synthesis of Intermediate 1
3.1.2. General Procedure for the Synthesis of Intermediates 2 and 3
3.1.3. General Procedure for the Synthesis of Intermediate 4
3.1.4. General Procedure for the Synthesis of Target Compounds W1–W20
3.2. Antifungal Activity Bioassay In Vitro
3.3. Antifungal Bioassay In Vivo
3.4. Scanning Electron Microscope (SEM) Observation
3.5. Determination of Cell Membrane Permeability of W12 to S. sclerotiorum
3.6. Determination of Cytoplasmic Leakage of W12 to S. sclerotiorum
3.7. Determination of Malondialdehyde Content
3.8. Molecular Docking
4. Conclusions
Supplementary Materials
Author Contributions
Funding
Institutional Review Board Statement
Data Availability Statement
Conflicts of Interest
References
- Savary, S.; Teng, P.S.; Willocquet, L.; Nutter, F.W., Jr. Quantification and modeling of crop losses: A review of purposes. Annu. Rev. Phytopathol. 2006, 44, 89–112. [Google Scholar] [CrossRef]
- Gonzalez-Fernandez, R.; Jorrin-Novo, J.V. Contribution of proteomics to the study of plant pathogenic fungi. J. Proteome Res. 2012, 11, 3–16. [Google Scholar] [CrossRef]
- Li, H.; Wen, L.; Liu, K.; Guan, C.Y. Research Progress on Resistance Mechanism of Brassica napus to Sclerotinia sclerotiorum. Crop Res. 2015, 29, 84–90. [Google Scholar] [CrossRef]
- Peng, J.Y.; Sang, H.; Proffer, T.J.; Gleason, J.; Outwater, C.A.; Jung, G.; Sundin, G.W. A Method for the Examination of SDHI Fungicide Resistance Mechanisms in Phytopathogenic Fungi Using a Heterologous Expression System in Sclerotinia sclerotiorum. Phytopathology 2021, 111, 819–830. [Google Scholar] [CrossRef]
- Wu, J.; Yin, H.L.; Lin, L.; Liu, D.X.; Ren, S.C.; Zhang, W.J.; Meng, W.C.; Chen, P.P.; Sun, Q.F.; Fang, Y.J.; et al. Host-induced gene silencing of multiple pathogenic factors of Sclerotinia sclerotiorum confers resistance to Sclerotinia rot in Brassica napus. Crop J. 2022, 10, 661–671. [Google Scholar] [CrossRef]
- Saulle, C.C.; Claus, A.; Sales, L.D.A.; Gonçalves, A.G.; Ducatti, D.R.B.; Noseda, M.D. Photoinactivation of Colletotrichum truncatum, Corynespora cassiicola, Sclerotinia sclerotiorum and Rhizoctonia solani in soybean seeds by cationic porphyrins. Plant. Pathol. 2022, 72, 67–75. [Google Scholar] [CrossRef]
- Wang, X.F.; Cao, L.F.; Zhang, D.F.; Liu, Y.S. Inhibitory effect of low molecular weight chitosan on kiwifruit gray mold caused by Botrytis cinerea. J. Hefei Univ. Tech. 2019, 42, 1563–1568. [Google Scholar] [CrossRef]
- Wang, K.Y.; Zhang, X.; Shao, X.; Wei, Y.; Xu, F.; Wang, H. Flavonoids from Sedum aizoon L. inhibit Botrytis cinerea by negatively affecting cell membrane lipid metabolism. Appl. Microbiol. Biot. 2022, 106, 7139–7151. [Google Scholar] [CrossRef]
- Nunes, C.A. Biological control of postharvest diseases of fruit. Eur. J. Plant Pathol. 2011, 133, 181–196. [Google Scholar] [CrossRef]
- Ribas, E.R.A.D.; Spolti, P.; Del Ponte, E.M.; Donato, K.Z.; Schrekker, H.; Fuentefria, A.M. Is the emergence of fungal resistance to medical triazoles related to their use in the agroecosystems? A mini review. Braz. J. Microbiol. 2016, 47, 793–799. [Google Scholar] [CrossRef]
- Luo, H.; Liu, J.J.; Jin, L.H.; Hu, D.Y.; Chen, Z.; Yang, S.; Wu, J.; Song, B.A. Synthesis and antiviral bioactivity of novel (1E,4E)-1-aryl-5-(2-(quinazolin-4-yloxy)phenyl)-1,4-pentadien-3- one derivatives. Eur. J. Med. Chem. 2013, 63, 662–669. [Google Scholar] [CrossRef]
- Zhang, J.P.; Li, Q.; Zhang, C.; Li, P.; Chen, L.J.; Wang, Y.H.; Ruan, X.H.; Xiao, W.; Xue, W. Synthesis, antibacterial, and antiviral activities of novel penta-1,4-dien-3-one derivatives containing a benzotriazin-4(3H)-one moiety. Chem. Pap. 2018, 72, 2193–2202. [Google Scholar] [CrossRef]
- Yang, X.J.; Miao, F.; Yao, Y.; Cao, F.J.; Yang, R.; Ma, Y.N.; Qin, B.F.; Zhou, L. In vitro antifungal activity of sanguinarine and chelerythrine derivatives against phytopathogenic fungi. Molecules 2012, 17, 13026. [Google Scholar] [CrossRef]
- Chen, M.H.; Hu, D.Y.; Li, X.Y.; Yang, S.; Zhang, W.Y.; Li, P.; Song, B.A. Antiviral activity and interaction mechanisms study of novel glucopyranoside derivatives. Bioorg. Med. Chem. Lett. 2015, 25, 3840–3844. [Google Scholar] [CrossRef]
- Tang, X.; Su, S.J.; Li, Q.; He, J.; Chen, M.; Chen, Y.; Wu, J.; Jiang, S.C.; Xue, W. Synthesis and bioactivity evaluation of penta-1,4-diene-3-one oxime ether derivatives. J. Pestic. Sci. 2019, 44, 242–248. [Google Scholar] [CrossRef]
- Chen, M.; Wang, Y.H.; Su, S.J.; Chen, Y.; Peng, F.; Zhou, Q.; Liu, T.T.; Luo, H.; Wang, H.; Xue, W. Synthesis and biological evaluation of 1,4-pentadien-3-one derivatives containing 1,2,4-triazole. J. Saudi Chem. Soc. 2020, 24, 765–776. [Google Scholar] [CrossRef]
- Han, Y.; Ding, Y.; Xie, D.D.; Hu, D.Y.; Li, P.; Li, X.Y.; Xue, W.; Jin, L.H.; Song, B.A. Design, synthesis, and antiviral activity of novel rutin derivatives containing 1,4-pentadien-3-one moiety. Eur. J. Med. Chem. 2015, 92, 732–737. [Google Scholar] [CrossRef]
- Zhou, Q.; Zhou, Y.X.; Zhu, Y.Y.; Gong, C.Y.; Wu, Y.J.; Xue, W. Design, Synthesis, and Biological Evaluation of Novel 1,4-Pentadien-3-one Derivatives Containing a Sulfonamide Moiety. J. Agric. Food Chem. 2022, 70, 16096–16105. [Google Scholar] [CrossRef]
- Peng, J.W.; Yin, X.D.; Li, H.; Ma, K.Y.; Zhang, Z.J.; Zhou, R.; Wang, Y.L.; Hu, G.F.; Liu, Y.Q. Design, Synthesis, and Structure-Activity Relationship of Quinazolinone Derivatives as Potential Fungicides. J. Agric. Food Chem. 2021, 69, 4604–4614. [Google Scholar] [CrossRef]
- Wang, H.X.; Liu, H.Y.; Li, W.; Zhang, S.; Wu, Z.; Li, X.; Li, C.W.; Liu, Y.M.; Chen, B.Q. Design, synthesis, antiproliferative and antibacterial evaluation of quinazolinone derivatives. Med. Chem. Res. 2018, 28, 203–214. [Google Scholar] [CrossRef]
- El-Bordany, E.A.; Ali, R.S. Synthesis of New Benzoxazinone, Quinazolinone, and Pyrazoloquinazolinone Derivatives and Evaluation of Their Cytotoxic Activity Against Human Breast Cancer Cells. J. Heterocycl. Chem. 2018, 55, 1223–1231. [Google Scholar] [CrossRef]
- Wang, X.; Li, P.; Li, Z.; Yin, J.; He, M.; Xue, W.; Chen, Z.; Song, B.A. Synthesis and bioactivity evaluation of novel arylimines containing a 3-aminoethyl-2-[(p- trifluoromethoxy)anilino]-4(3H)-quinazolinone moiety. J. Agric. Food Chem. 2013, 61, 9575–9582. [Google Scholar] [CrossRef]
- Liu, T.T.; Peng, F.; Cao, X.; Liu, F.; Wang, Q.F.; Liu, L.W.; Xue, W. Design, Synthesis, Antibacterial Activity, Antiviral Activity, and Mechanism of Myricetin Derivatives Containing a Quinazolinone Moiety. ACS Omega 2021, 6, 30826–30833. [Google Scholar] [CrossRef]
- El-Sayed, A.A.; Ismail, M.F.; Amr, A.E.E.; Naglah, A.M. Synthesis, Antiproliferative, and Antioxidant Evaluation of 2-Pentylquinazolin-4(3H)-one (thione) Derivatives with DFT Study. Molecules 2019, 24, 3787. [Google Scholar] [CrossRef]
- Zhang, L.; Chen, Q.; Li, X.Q.; Wu, S.Q.; Wan, J.L.; Ouyang, G.P. Synthesis and Antibacterial Activity of 2-substitued-(3-pyridyl)-quinazolinone Derivatives. J. Heterocycl. Chem. 2018, 55, 743–749. [Google Scholar] [CrossRef]
- Hao, Y.N.; Wang, K.H.; Wang, Z.W.; Liu, Y.X.; Ma, D.J.; Wang, Q.M. Luotonin A and Its Derivatives as Novel Antiviral and Antiphytopathogenic Fungus Agents. J. Agric. Food Chem. 2020, 68, 8764–8773. [Google Scholar] [CrossRef]
- Ma, J.; Li, P.; Li, X.; Shi, Q.; Wan, Z.; Hu, D.Y.; Jin, L.H.; Song, B.A. Synthesis and antiviral bioactivity of novel 3-((2-((1E,4E)-3-oxo-5-arylpenta-1,4-dien-1-yl)phenoxy)methyl)-4(3H)-qu inazolinon derivatives. J. Agric. Food Chem. 2014, 62, 8928–8934. [Google Scholar] [CrossRef]
- Liu, T.T.; Peng, F.; Zhu, Y.; Cao, X.; Wang, Q.F.; Liu, F.; Liu, L.W.; Xue, W. Design, synthesis, biological activity evaluation and mechanism of action of myricetin derivatives containing thioether quinazolinone. Arab. J. Chem. 2022, 15, 104019. [Google Scholar] [CrossRef]
- Wang, L.L.; Li, C.; Zhang, Y.Y.; Qiao, C.H.; Ye, Y.H. Synthesis and biological evaluation of benzofuroxan derivatives as fungicides against phytopathogenic fungi. J. Agric. Food Chem. 2013, 61, 8632–8640. [Google Scholar] [CrossRef]
- Saroj, A.; Pragadheesh, V.; Yadav, A.; Singh, S.C.; Samad, A.; Negi, A.S.; Chanotiya, C.S. Anti-phytopathogenic activity of Syzygium cumini essential oil, hydrocarbon fractions and its novel constituents. Ind. Crop Prod. 2015, 74, 327–335. [Google Scholar] [CrossRef]
- Yin, X.D.; Ma, K.Y.; Wang, Y.L.; Sun, Y.; Shang, X.F.; Zhao, Z.M.; Wang, R.X.; Chen, Y.J.; Zhu, J.K.; Liu, Y.Q. Design, Synthesis, and Antifungal Evaluation of 8-Hydroxyquinoline Metal Complexes against Phytopathogenic Fungi. J. Agric. Food Chem. 2020, 68, 11096–11104. [Google Scholar] [CrossRef]
- Liu, D.; Luo, L.; Wang, Z.X.; Ma, X.Y.; Gan, X.H. Design, Synthesis and Antifungal/Nematicidal Activity of Novel 1,2,4-Oxadiazole Derivatives Containing Amide Fragments. Int. J. Mol. Sci. 2022, 23, 1596. [Google Scholar] [CrossRef] [PubMed]
- Zhou, Y.; Gong, G.S.; Cui, Y.L.; Zhang, D.X.; Chang, X.L.; Hu, R.P.; Liu, N.; Sun, X.F. Identification of Botryosphaeriaceae Species Causing Kiwifruit Rot in Sichuan Province, China. Plant Dis. 2015, 99, 699–708. [Google Scholar] [CrossRef] [PubMed]
- Zhang, Z.J.; Jiang, Z.Y.; Zhu, Q.; Zhong, G.H. Discovery of beta-Carboline Oxadiazole Derivatives as Fungicidal Agents against Rice Sheath Blight. J. Agric. Food Chem. 2018, 66, 9598–9607. [Google Scholar] [CrossRef]
- Shang, X.F.; Zhao, Z.M.; Li, J.C.; Yang, G.Z.; Liu, Y.Q.; Dai, L.X.; Zhang, Z.J.; Yang, Z.G.; Miao, X.L.; Yang, C.J.; et al. Insecticidal and antifungal activities of Rheum palmatum L. anthraquinones and structurally related compounds. Ind. Crop. Prod. 2019, 137, 508–520. [Google Scholar] [CrossRef]
- Efenberger-Szmechtyk, M.; Nowak, A.; Czyzowska, A.; Sniadowska, M.; Otlewska, A.; Zyzelewicz, D. Antibacterial mechanisms of Aronia melanocarpa (Michx.), Chaenomeles superba Lindl. And Cornus mas L. leaf extracts. Food Chem. 2021, 350, 129218. [Google Scholar] [CrossRef]
- Ma, D.Y.; Ji, D.C.; Zhang, Z.Q.; Li, B.Q.; Qin, G.Z.; Xu, Y.; Chen, T.; Tian, S.P. Efficacy of rapamycin in modulating autophagic activity of Botrytis cinerea for controlling gray mold. Postharvest Biol. Technol. 2019, 150, 158–165. [Google Scholar] [CrossRef]
- Zafari, M.; Ebadi, A.; Jahanbakhsh, S.; Sedghi, M. Safflower (Carthamus tinctorius) Biochemical Properties, Yield, and Oil Content Affected by 24-Epibrassinosteroid and Genotype under Drought Stress. J. Agric. Food Chem. 2020, 68, 6040–6047. [Google Scholar] [CrossRef]
- Asogwa, F.C.; Agwamba, E.C.; Louis, H.; Muozie, M.C.; Benjamin, I.; Gber, T.E.; Mathias, G.E.; Adeyinka, A.S.; Ikeuba, A.I. Structural benchmarking, density functional theory simulation, Spectrosco pic investigation and molecular docking of N-(1H-pyrrol-2-yl)methylene)-4-methylaniline as castration-resistant prostate cancer chemotherapeutic agent. Chem. Phys. Impact 2022, 5, 100091. [Google Scholar] [CrossRef]

| Compounds | Inhibition Rate (%) a | |||||||||
|---|---|---|---|---|---|---|---|---|---|---|
| Bdb | Rs | Bc | Ss | Ps | Pc | Fa | Fe | Nd | Cg | |
| W1 | 2.8 ± 1.1 | 19.2 ± 1.7 | 3.1 ± 0.8 | 17.4 ± 1.1 | 14.9 ± 1.1 | 45.7 ± 0.9 | 15.8 ± 1.2 | 12.1 ± 2.6 | 11.2 ± 1.1 | 9.6 ± 3.2 |
| W2 | 6.1 ± 4.3 | 29.2 ± 1.7 | 3.9 ± 1.6 | 16.6 ± 0.8 | 15.3 ± 0.9 | 35.1 ± 3.1 | 24.2 ± 1.1 | 13.3 ± 1.2 | 14.6 ± 1.6 | 11.2 ± 2.3 |
| W3 | 5.6 ± 0.1 | 33.3 ± 4.9 | 4.6 ± 0.8 | 15.5 ± 1.6 | 9.2 ± 2.3 | 44.9 ± 1.2 | 18.3 ± 1.1 | 12.1 ± 1.7 | 7.0 ± 1.6 | 17.1 ± 1.6 |
| W4 | 8.5 ± 1.1 | 24.3 ± 1.6 | 3.5 ± 2.1 | 7.9 ± 1.1 | 12.5 ± 4.1 | 33.1 ± 1.1 | 10.0 ± 2.5 | 10.4 ± 1.7 | 12.1 ± 1.6 | 5.0 ± 1.9 |
| W5 | 2.4 ± 0.1 | 23.5 ± 8.2 | 5.8 ± 2.2 | 9.4 ± 0.2 | 10.8 ± 1.9 | 30.6 ± 1.4 | 13.3 ± 1.1 | 15.8 ± 1.8 | 15.0 ± 1.4 | 7.1 ± 1.6 |
| W6 | 2.9 ± 1.2 | 19.2 ± 1.7 | 5.0 ± 0.1 | 14.3 ± 0.8 | 2.4 ± 1.2 | 34.3 ± 1.7 | 10.0 ± 2.0 | 10.4 ± 1.7 | 22.5 ± 1.9 | 17.5 ± 1.9 |
| W7 | 2.2 ± 0.4 | 25.4 ± 1.1 | 6.2 ± 1.1 | 9.1 ± 0.8 | 8.4 ± 1.5 | 26.9 ± 3.3 | 9.2 ± 1.2 | 13.7 ± 1.9 | 12.9 ± 2.5 | 5.8 ± 3.5 |
| W8 | 2.1 ± 0.5 | 21.5 ± 1.7 | 4.3 ± 1.0 | 9.4 ± 0.1 | 8.3 ± 1.9 | 27.4 ± 1.1 | 13.7 ± 1.2 | 10.8 ± 1.2 | 7.9 ± 1.6 | 2.1 ± 1.6 |
| W9 | 4.8 ± 2.2 | 19.2 ± 2.2 | 6.2 ± 2.2 | 8.3 ± 1.1 | 6.4 ± 1.6 | 30.6 ± 2.7 | 5.0 ± 1.4 | 3.7 ± 1.2 | 25.8 ± 1.1 | 3.7 ± 1.8 |
| W10 | 2.5 ± 0.2 | 18.0 ± 0.9 | 5.7 ± 1.7 | 18.3 ± 1.1 | 5.2 ± 1.8 | 31.0 ± 3.3 | 9.2 ± 1.8 | 7.9 ± 2.6 | 18.7 ± 1.8 | 25.4 ± 1.6 |
| W11 | 32.4 ± 0.3 | 22.2 ± 1.1 | 33.9 ± 1.8 | 47.2 ± 0.3 | 26.4 ± 0.9 | 35.5 ± 1.1 | 27.5 ± 1.4 | 15.8 ± 2.3 | 10.0 ± 1.9 | 20.8 ± 1.1 |
| W12 | 84.9 ± 1.7 | 100 | 50.2 ± 1.1 | 100 | 100 | 91.1 ± 1.6 | 68.7 ± 1.2 | 80.2 ± 2.0 | 77.1 ± 1.6 | 57.5 ± 1.9 |
| W13 | 23.7 ± 1.1 | 18.8 ± 1.2 | 46.9 ± 0.9 | 52.8 ± 1.1 | 33.3 ± 1.4 | 43.9 ± 1.4 | 45.4 ± 1.7 | 20.4 ± 1.7 | 37.5 ± 1.4 | 36.2 ± 1.2 |
| W14 | 2.6 ± 1.1 | 16.5 ± 1.1 | 6.2 ± 1.8 | 15.9 ± 0.8 | 4.4 ± 1.1 | 26.5 ± 2.4 | 21.6 ± 1.2 | 15.0 ± 2.0 | 5.8 ± 1.7 | 14.2 ± 1.8 |
| W15 | 3.9 ± 0.5 | 9.8 ± 1.1 | 3.1 ± 0.8 | 17.7 ± 1.1 | 27.7 ± 0.1 | 32.2 ± 2.3 | 17.5 ± 1.4 | 12.5 ± 1.4 | 23.3 ± 1.7 | 5.8 ± 1.8 |
| W16 | 13.2 ± 1.2 | 16.1 ± 1.1 | 6.2 ± 2.2 | 11.3 ± 2.0 | 17.3 ± 1.1 | 22.5 ± 2.2 | 9.6 ± 2.2 | 16.6 ± 1.1 | 29.6 ± 1.6 | 34.6 ± 1.6 |
| W17 | 46.5 ± 0.5 | 79.1 ± 0.3 | 10.8 ± 1.1 | 100 | 100 | 49.1 ± 1.9 | 11.6 ± 1.8 | 58.7 ± 1.2 | 62.9 ± 1.6 | 42.1 ± 1.6 |
| W18 | 32.8 ± 0.1 | 29.8 ± 0.8 | 8.1 ± 1.1 | 100 | 48.6 ± 2.3 | 43.7 ± 1.4 | 33.3 ± 1.1 | 25.4 ± 1.7 | 36.2 ± 1.2 | 43.8 ± 1.2 |
| W19 | 4.9 ± 0.9 | 30.2 ± 1.1 | 5.8 ± 1.9 | 100 | 28.5 ± 1.1 | 35.1 ± 1.2 | 10.4 ± 1.7 | 24.2 ± 2.3 | 10.4 ± 2.5 | 12.1 ± 1.6 |
| W20 | 6.1 ± 1.1 | 24.3 ± 1.6 | 11.9 ± 1.8 | 7.9 ± 1.1 | 44.9 ± 1.6 | 45.1 ± 1.7 | 14.6 ± 1.7 | 20.4 ± 1.7 | 8.7 ± 1.8 | 19.2 ± 1.1 |
| Azoxystrobin c | 56.3 ± 2.6 | 41.2 ± 1.9 | 61.7 ± 1.5 | 56.6 ± 1.6 | 75.9 ± 0.2 | 44.1 ± 2.6 | 51.2 ± 1.9 | 75.8 ± 1.1 | 93.3 ± 1.1 | 74.6 ± 1.6 |
| Compound | Phytopathogen | Regression Equation | EC50 (μg/mL) | r |
|---|---|---|---|---|
| W12 | Ss | Y = 0.89X + 5.13 | 0.70 d | 0.98 |
| W17 | Ss | Y = 0.87X + 3.93 | 16.22 b | 0.97 |
| W18 | Ss | Y = 0.39X + 4.34 | 45.30 a | 0.96 |
| Azoxystrobin c | Ss | Y = 1.11X + 3.95 | 8.51 c | 0.97 |
| W12 | Ps | Y = 0.96X + 3.91 | 3.84 c | 0.95 |
| W17 | Ps | Y = 0.21X + 4.72 | 18.80 a | 0.99 |
| Azoxystrobin | Ps | Y = 0.61X + 4.24 | 17.25 b | 0.97 |
| W12 | Rs | Y = 0.54X + 4.68 | 14.04 c | 0.99 |
| W17 | Rs | Y = 0.36X + 4.47 | 27.82 a | 0.99 |
| Azoxystrobin | Rs | Y = 0.73X + 4.01 | 22.25 b | 0.99 |
| Compound | Concentration (μg/mL) | Curative Effect | Protective Effect | ||
|---|---|---|---|---|---|
| Lesion Length (mm ± SD) | Controlling Efficacy (%) | Lesion Length (mm ± SD) | Controlling Efficacy (%) | ||
| W12 | 100 | 7.5 ± 0.3 e | 87.6 | 6.1 ± 0.6 d | 91.7 |
| 50 | 9.3 ± 0.6 d | 78.8 | 6.7 ± 0.8 cd | 87.3 | |
| 25 | 15.1 ± 0.4 b | 50.2 | 8.7 ± 0.2 b | 72.3 | |
| Azoxystrobin c | 100 | 7.2 ± 0.2 e | 88.2 | 6.3 ± 0.4 d | 90.2 |
| 50 | 7.9 ± 0.9 e | 85.7 | 7.7 ± 0.3 bc | 79.8 | |
| 25 | 10.5 ± 0.8 c | 72.1 | 8.1 ± 0.5 b | 76.8 | |
| Control | 0 | 25.3 ± 0.2 a | 18.4 ± 0.7 a | ||
| Compound | Concentration (μg/mL) | Curative Effect | Protective Effect | ||
|---|---|---|---|---|---|
| Lesion Length (mm ± SD) | Controlling Efficacy (%) | Lesion Length (mm ± SD) | Controlling Efficacy (%) | ||
| W12 | 200 | 11.4 ± 0.7 c | 82.3 | 6.3 ± 0.9 d | 96.2 |
| 100 | 21.4 ± 0.6 b | 54.6 | 9.8 ± 0.8 c | 86.4 | |
| Azoxystrobin c | 200 | 8.0 ± 0.5 d | 91.7 | 6.9 ± 0.3 d | 94.6 |
| 100 | 12.3 ± 1.0 c | 79.8 | 12.1 ± 1.1 b | 80.0 | |
| Control | 0 | 41.2 ± 1.5 a | 40.5 ± 10.9 a | ||
Disclaimer/Publisher’s Note: The statements, opinions and data contained in all publications are solely those of the individual author(s) and contributor(s) and not of MDPI and/or the editor(s). MDPI and/or the editor(s) disclaim responsibility for any injury to people or property resulting from any ideas, methods, instructions or products referred to in the content. |
© 2023 by the authors. Licensee MDPI, Basel, Switzerland. This article is an open access article distributed under the terms and conditions of the Creative Commons Attribution (CC BY) license (https://creativecommons.org/licenses/by/4.0/).
Share and Cite
Zhou, R.; Zhan, W.; Yuan, C.; Zhang, T.; Mao, P.; Sun, Z.; An, Y.; Xue, W. Design, Synthesis and Antifungal Activity of Novel 1,4-Pentadiene-3-one Containing Quinazolinone. Int. J. Mol. Sci. 2023, 24, 2599. https://doi.org/10.3390/ijms24032599
Zhou R, Zhan W, Yuan C, Zhang T, Mao P, Sun Z, An Y, Xue W. Design, Synthesis and Antifungal Activity of Novel 1,4-Pentadiene-3-one Containing Quinazolinone. International Journal of Molecular Sciences. 2023; 24(3):2599. https://doi.org/10.3390/ijms24032599
Chicago/Turabian StyleZhou, Ran, Wenliang Zhan, Chunmei Yuan, Tao Zhang, Piao Mao, Zhiling Sun, Yousan An, and Wei Xue. 2023. "Design, Synthesis and Antifungal Activity of Novel 1,4-Pentadiene-3-one Containing Quinazolinone" International Journal of Molecular Sciences 24, no. 3: 2599. https://doi.org/10.3390/ijms24032599
APA StyleZhou, R., Zhan, W., Yuan, C., Zhang, T., Mao, P., Sun, Z., An, Y., & Xue, W. (2023). Design, Synthesis and Antifungal Activity of Novel 1,4-Pentadiene-3-one Containing Quinazolinone. International Journal of Molecular Sciences, 24(3), 2599. https://doi.org/10.3390/ijms24032599

